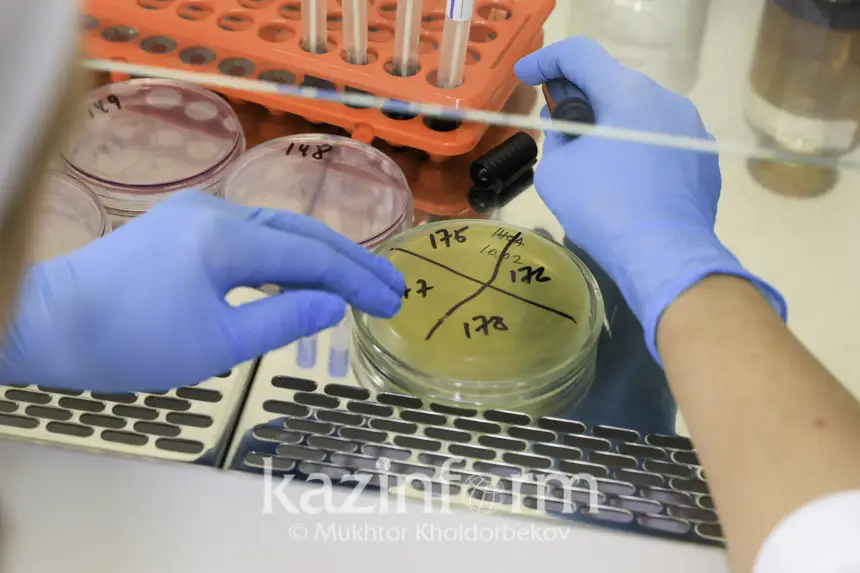

От молока до винно-водочных изделий: Где проверяют качество и безопасность казахстанских продуктов

Услугами Центра могут воспользоваться все, кто хочет проверить определенный продукт на содержание сомнительных веществ и те, кто хочет экспортировать свой товар.

Масло и вино
В отделе хроматографии на газовом хроматографе изучают вино-водочную, спиртную, масложировую продукцию. Их проверяют на фальсификацию, то есть, действительно ли масло является маслом или в нем есть примеси спреда. По спиртной и вино-водочной продукции определяется наличие в них токсичной примеси, то есть, является ли продукция контрафактной, есть ли примеси технических спиртов. Также можно определить частоту, наличие или отсутствие метилового спирта в антифризах, зимних омывающих жидкостях для стекол машин.

Проводятся также различные исследования, например, на наличие или отсутствие антибиотиков, гормонов в мясной продукции, в мясомолочной продукции, определение микротоксинов.

«Гормоны хоть и наносят наименьший вред, но могут привести к нарушению метаболизма. При откорме сельскохозяйственных животных иногда не соблюдается правило убоя. Если скоту прописали лекарственные ветеринарные препараты с содержанием гормона, но не выдержали определенный срок и сразу же забили через несколько дней, гормоны откладываются в жировых тканях. А когда человек употребляет это мясо, у него может начаться сбой в обмене веществ. То есть, это приводит либо к ожирению, либо к гормональным перестройкам. Спектр антибиотиков тоже огромный. Есть те, что употребляются человеком, есть антибиотики запаса, антибиотики ветеринарного применения. Все они требуют экспертизы, поскольку при употреблении человеком вырабатывается антибиотикорезистентность. В некоторых случаях это приводит к мутированию в имеющихся в человеке бактериях. Мало того, что появляется устойчивость, к тому же это приводит к изменению и появлению новых штаммов», - пояснил химик-лаборант.

Выявление ГМО или ДНК животного
В бактериологическом отделении имеется отдельная ПЦР-лаборатория, где изучается ДНК любой продукции. Здесь можно узнать, есть ли в составе продукта ГМО или использовалось ли мясо определенного животного: свинина, конина, козлятина, курица, говядина.

«В основном приносят пшеницу, зерно для исследования на ГМО и транспортировки за пределы Казахстана. Крупы, которые мы исследуем, в основном экспортируют в Россию, Афганистан, Турцию, страны Европы, даже в Италию. Очень много приносят мясной продукции, колбасные изделия, чтобы проверить на халяльность, на наличие спирта или ДНК свинины. Лучше не есть колбасы, в них очень много содержится специй. Самый дешевый продукт – свиной белок. Поэтому приносят нам, чтобы мы проверили, есть ли в составе свиной ДНК или нет. Мы даем точные результаты. Мы прошли сличительный образец в Великобритании для подтверждения того, что выдаем достоверные результаты, также проводим сличительные анализы с городским СЭС», - пояснила врач-бактериолог ПЦР-лаборатории Алия Ибраева.

Каждая продукция поступает в стерильное окно. Из рук в руки не передается, чтобы не попали бактерии. Все исследования проводятся в чистой стерильной зоне. Сначала в лаборатории выделяют ДНК продукции, эта процедура занимает полдня. После этого передают в следующее окно, чтобы перевести во вторую зону. Так выделенная ДНК поступает в зону скрининга. После скрининга все продукты загружают на анализатор.

«Выделенный продукт помещают в микропробирки, а затем загружают в анализатор. В течение 40 минут он уже считывает и показывает волны: есть ли ДНК, который мы ищем или нет. На каждый выделенный ДНК есть свой расходный материал. Порой приносят и молочные продукты и просят прописать, что в составе есть говяжье молоко. Также в молоко добавляют всякие специи. В основном их добавляют, чтобы молоко не испортилось», - добавила Алия Ибраева.

«Вода просто в виде Н2О неполезная»
«Имеется прибор для определения индекса токсичности. Допустим, вы покупаете крема. Перед продажей их проверяют, насколько они токсичные. Еще на одном приборе определяются альфа, бета и гамма излучения. Косметические средства, любые продукты питания, вода, почва – все можно проверить с помощью радиологических исследований. Когда начинают закладывать фундамент для дома, перед тем, как строить здание, мы проверяем почву, чтобы здание не стояло там, где, возможно, есть фоновое излучение», - рассказала химик-лаборант Инара Ищанова.

Здесь могут определить, можно ли пить воду из скважины или нет.
«Вода — это не просто Н2О, это состав ионов кальция, магния, натрия, сульфатов, нитритов. Все, что есть в воде, раскладываем на ее составные части и узнаем, что содержится в воде. Вода просто в виде Н2О неполезная. Когда есть соли, получаем определенную полезность. Один из интересных приборов – винный анализатор. Почти все вина считаются сульфатсодержащими. Это необходимо для хранения вин. Есть определенные нормы, которые нельзя превышать. Этот прибор показывает, соответствует ли нормам или нет», - пояснила химик-лаборант.

Близок ли продукт к порче: как выяснить
В эту лабораторию производители могут принести любой продукт, чтобы определить срок годности перед продажей. Как мы в домашних условиях можем проверить через сколько дней испортится продукт? Вы просто оставляете молоко в теплой комнате и смотрите, через сколько дней испортится вкус. Однако в лабораторных условиях выяснить это очень просто.

«Как мы определяем, что срок годности любого продукта? Он стоит в определенных условиях. Мы ускоряем эти условия за счет того, что поднимаем давление, добавляем кислород и скорость, продукт начинает быстрее портиться. За счет этого мы строим калибровочный график и понимаем, сколько дней продукт может долго храниться. Допустим, завод запускает новую линию масла. Это шоколадное масло, и мы не знаем, какой у него будет срок годности. На этом приборе срок годности определяется быстрее», - пояснила Инара Ищанова.

На одном из приборов определяют массовую долю жира в молоке. Еще на одном оборудовании – выявляют содержание ртути в продуктах питания.

«Также мы определяем тяжелые металлы в пищевых продуктах, в воде, в почве. Есть нормы технического регламента для всех продуктов питания на содержание тяжелых металлов. Каждый продукт должен соответствовать нормам. Допустим, в норме содержание свинца в продуктах не должно превышать 0,1. Когда в страну заходит любой продукт питания, он должен пройти проверку на соответствие ТРТС, чтобы его можно было продавать, чтобы был безопасен для людей», - отметила химик-лаборант.

В отдельной лаборатории проверяется микробиологическая безопасность пищевых продуктов, воды. И это только часть исследований, проводимых в Центре санитарно-эпидемиологической экспертизы Медицинского Центра УДП РК. Помимо этого, здесь изучают причины и условия возникновения инфекционных паразитарных заболеваний и пищевых отравлений, апробируются и внедряются новые приборы и лабораторное оборудование, методики лабораторных исследований и замеров.




